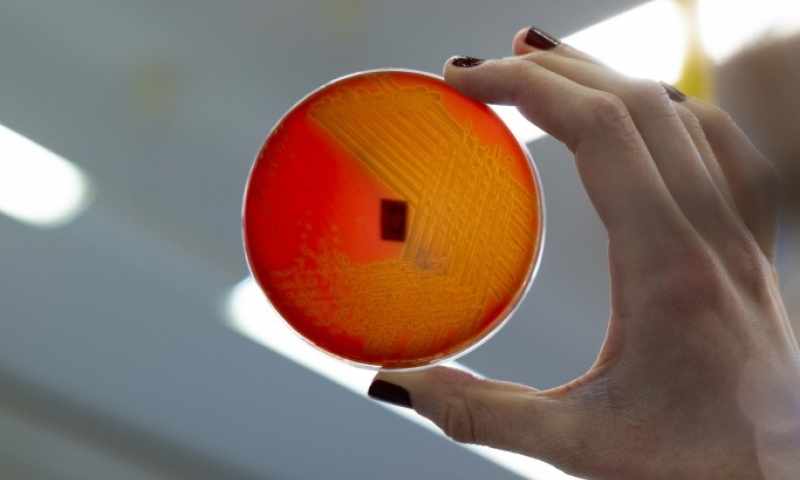
VŠCHT

Laboratorní cvičení žáků GO na VŠCHT v Praze
Naši studenti získali možnost zúčastnit se akce na Vysoké škole chemicko-technologické Praha, která nese název: Poznej vědu v akci. Dvě skupiny chemických nadšenců z naší školy tak zakusilo, jaké to je být vědcem v profesionálních laboratořích.
Jeden den poznali spektrometrickou laboratoř, ve které prováděli testování alkoholických nápojů na přítomnost metanolu. Ocitli se tak v rolích pracovníků, kteří měli tento nelehký úkol na starosti při poslední metanolové kauze.
Druhá skupina se pak další den stala mikrobiology, kteří pátrají po patogenech v potravinách. Naučili se tak poznávat mikroorganismy a jejich projevy v lidském těle.
Díky naší spolupráci s VŠCHT Praha už se nyní těšíme na to, že si v brzké době vyzkoušíme také další laboratorní práce, které nám tato škola umožní realizovat.
Ing. Miloš Krejčí